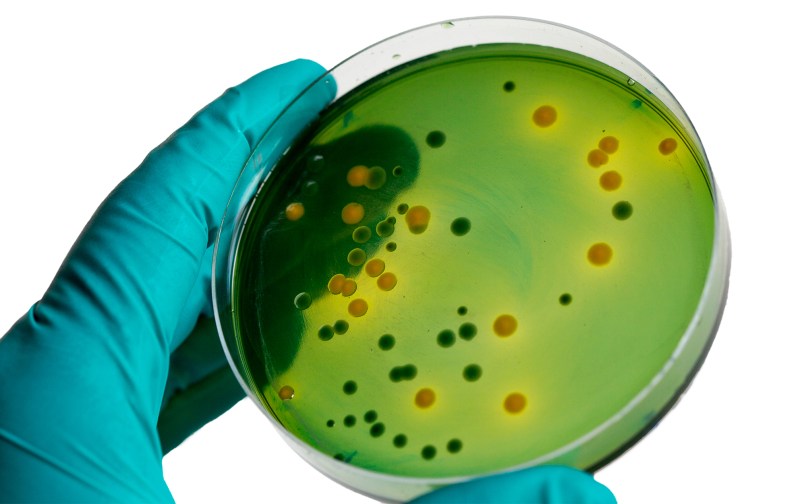
Pulpite periodontitis tooth classification

Sex on Small Elastic Cunt Caries (53 photos)
---

Prevention of dental diseases Poster

Destroyed tooth from caries

Elgidium pasta tooth protection against caries tube 75 ml

Phthorlak Belak

Sanbulleten oral hygiene

Hygiene of teeth and oral cavity memo

Caries microbes for children

What is the harmful sugar

Differential diagnosis of chronic periodontitis

A check from a dentist

Memo for children on oral cavity hygiene

Healthy and sick tooth

Cute tooth

Big Brother 0.13.0.007 Ann

Caries infographics

Chemistry sketches

Formation of caries vector

Multi -root pulpitis

Helen Parr Elasty

Caries treatment advertising

Compensated and decompensated form of caries

What is the lack of an element to decay of teeth

Caries prevention in children

Kiss with tongue

Streptococcus Mutans Caries

Gel Rox remineralizing before and after

Scheme of demineralization and remineralization of enamel

Insulin classification of drugs drug

Licking pussy close -up

Pathogenesis of Periimplantititis

Superficial fissure caries

Remineralization of enamel scheme

Cariose lesions of tooth caries

Professional oral hygiene

Pulpit tooth guttar

The size of the caries is average

The first molar of the upper jaw of the hillock

Seal drawing

Sowing bacteria per cup of Petri

Giant girl swallows people

Grinding and polishing of teeth
Pulpite periodontitis tooth classification

How is the IPC going to the Ministry of Internal Affairs when entering work

Caries pulpite periodontitis

Caries prevention

Therapist's conclusion before surgery

Caries pulpite periodontitis table

Dentist cute drawing





Related porn
Add comment




